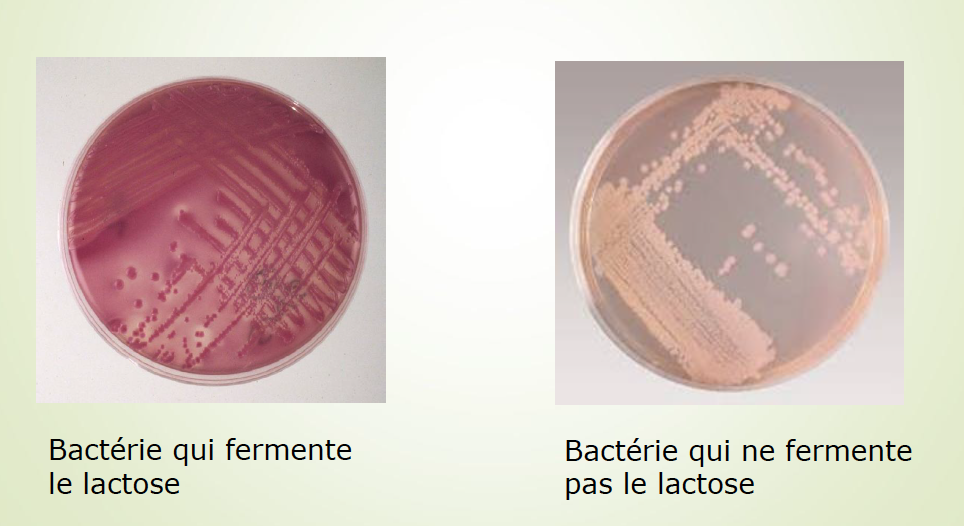

Les Eschericha coli sont quel type de bactéries?
Des bacilles à Gram négatif
Quelle est la famille de E. Coli?
Famille des Entérobactéries
Quels sont les 2 rôles des bactéries de la famille des Entérobactéries?
Quels sont les trois environnements où l’on retrouve E. coli?
Quels sont les 2 tableaux cliniques de E. coli?
Donner 10 caractéristiques cliniques de E. coli ?
Donner 13 bactéries de la famille des Entérobactéries
Donner 5 caractéristiques morphologiques de E.coli
Donner 4 caractéristiques de la culture de E coli
Quel milieux de culture différentiel et sélectif est le plus souvent utilisé?
Gélose MacConkey
⇒
Quel est l’arrangement de la paroi des bactéries à Gram négatif?

Quel est l’arragnement de la paroi des Entérobactéries?

Quelles sont les 4 caractéristiques de la paroi de E. coli ?
Donner 3 caractéristiques du LPS de la paroi de E. coli ?
Comparer la structure de la paroi des bactéries à Gram négatif et Gram positif

Décrire le lipide A présent dans la paroi de E. Coli
Décrire le core présent dans la paroi de E. coli (2)
Décrire les chaînes polysaccharidiques présentes dans la paroi de E. coli (2)
Quels sont les 3 effets biologiques de l’endotoxine ?
Décrire les effets biologiques par action indirecte de l’endotoxine
L’endotoxine est reconnue par le système immunitaire …
En faible quantité
⇒
Active la fièvre
En large quantité
⇒
Hypotension
Marginalisation des PMNs et des plaquettes (coagulation vasculaire disséminée)
Quelles sont les 7 toxines de E. Coli
Donner 3 caractéristiques des entérotoxinogènes
Quels sont les 2 types d’entérotoxinogènes?
Donner 4 caractéristiques de la toxine ST